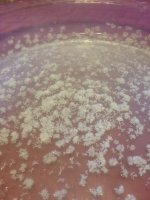
image.jpg

BobDobalina
Rising Star
- Merits
- 42
۩ said:What solvent would you use if you can't get naptha?
Coleman Lantern Fuel
Live Hongkong - Live Result HK - Live Draw HK - Live HK
Live Draw HK yang kami berikan merupakan pengeluaran hasil yang akurat, cepat dan resmi. Jadi keluaran yang kami berikan disini dapat dipercaya.
Zippo Fluid
Live Hongkong - Live Result HK - Live Draw HK - Live HK
Live Draw HK yang kami berikan merupakan pengeluaran hasil yang akurat, cepat dan resmi. Jadi keluaran yang kami berikan disini dapat dipercaya.
Ronsonol Lighter Fluid
Those are some alternative sources of Naphtha, be sure to check the MSDS if you want to try another option.
UPDATE - I finally got pure white crystals, it turns out freeze precipitation was counter productive in my case at least. I followed the tek and let them sit in a jar overnight, the next day there was a nice surprise waiting. Is there any advantage to freeze precip? The crystals without it were nice and fluffy, it almost looked like cotton after I scraped it.

 I freeze precipitated to get the remaining goodies out, although I got a lot of goo from the freeze precipitates.
I freeze precipitated to get the remaining goodies out, although I got a lot of goo from the freeze precipitates.